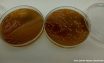

Sistema inédito de biorreatores monitora processos de compostagem em laboratório
A pesquisa agropecuária desenvolveu um sistema de biorreatores de bancada interligados que permite analisar com rapidez e precisão a eficiência de processos de compostagem, principal método para produção de fertilizantes orgânicos. O protótipo já foi validado no laboratório de biorreatores e bioprocessos da Embrapa Solos (RJ) com resultados bastante satisfatórios, e agora o ativo tecnológico está disponível para parceria com empresas interessadas em desenvolver interface e design mais funcionais e atrativos para ofertá-lo ao setor produtivo.
Um dos diferenciais do equipamento é a capacidade de realizar testes rápidos em laboratório na mistura que está sendo preparada para a compostagem. Com 1 Kg de uma combinação de resíduos é possível saber, em questão de horas, o seu potencial para os bioprocessos.
O laudo mostra o potencial de o material alcançar temperaturas entre 50 e 65 graus Celsius, ideais para o processo de compostagem, bem como a taxa de aeração (suprimento de oxigênio) exigida pela atividade de biodegradação. De acordo com os pesquisadores, mesmo os experimentos mais complexos podem ser avaliados em menos de dois meses.
“Biorreatores como esses existem em outros projetos e modelos, mas, no nosso caso, conseguimos a façanha inédita de ter 12 reatores em funcionamento ao mesmo tempo e em linha, com sensores de oxigênio e gás carbônico e controle de temperatura, tudo integrado. Um dos diferenciais desse sistema é que, com no máximo um volume de 50 litros de mistura de resíduo, é possível fazer um experimento completo, com combinações, tratamentos e repetições, coisa que a campo seria impossível”, explica o pesquisador Caio Teves Inácio, líder do projeto que criou o sistema na Embrapa Solos.
Inácio enfatiza que a geração de resíduos na agricultura e na agroindústria cresce na mesma proporção que a produção desses setores. Portanto, reaproveitar esses resíduos para o processo de compostagem, por exemplo, é importante para o meio ambiente e traz lucro aos produtores. “É uma questão de sustentabilidade. Nesse cenário, a tecnologia dos biorreatores de bancada ganha ainda mais relevância”, complementa.
Esses sistemas oferecem ainda um controle maior de todo o desenvolvimento experimental, possibilitando pesquisar com mais segurança e celeridade temas como degradação de agrotóxicos, perda de nitrogênio e eficiência do uso de inoculantes microbianos durante a compostagem.
Avanços tecnológicos ampliam o uso de biorreatores
Biorreatores são equipamentos amplamente utilizados na pesquisa e desenvolvimento nas áreas de biomedicina, biofármacos, bioenergia, biorremediação de resíduos e outros bioprocessos.
Inácio aponta que avanços na biotecnologia, em conexão com as tecnologias digitais e engenharia de equipamentos, permitiram nos últimos anos inovações importantes no campo tecnológico dos biorreatores, impulsionadas pela tendência de uso de fontes biológicas, orgânicas, renováveis e recicláveis em substituição à matéria-prima de origem não renovável, como as procedentes de matrizes fósseis e inorgânicas, que apresentam potencial elevado de impactos negativos ao meio ambiente.
O maior aproveitamento dos recursos biológicos e das moléculas bioativas de origem animal e vegetal tem representado importante potencial de inovação para a agricultura. No caso do reúso de resíduos rurais e da agroindústria para a produção de fertilizantes, por exemplo, indústria e agricultura têm se integrado em uma cadeia de produção de insumos de base biológica e renovável.
“O emprego da matéria orgânica, como insumo fertilizante e condicionante de solo, muito embora corresponda a uma prática tradicional na agricultura, tem demandado inovações para atender ao crescente interesse da indústria, dos agricultores e dos consumidores finais na obtenção de produtos com efeito melhorado em termos de nutrição e desempenho”, ressalta o pesquisador.
O aproveitamento mais eficaz dos resíduos orgânicos provenientes da agropecuária e da agroindústria passou a exigir processos de biotransformação para a produção de nutrientes vegetais com maior valor proteico e energético, além de comprovadamente seguros ao meio ambiente e à saúde humana. Com isso, aumentou o emprego dos biorreatores aeróbicos e anaeróbicos nos chamados bioprocessos, sejam de equipamentos de porte industrial ou de escala piloto e de bancada, como é o caso do ativo desenvolvido pela Embrapa.
Inácio explica que biorreatores em escala adequada à pesquisa e experimentação possibilitam a simulação de bioprocessos – como a compostagem aeróbica de resíduos orgânicos – que ocorrem em grandes leiras dispostas no meio ambiente. Por meio de equipamentos em escala de bancada, é possível simular, em ambiente controlado de laboratório, a repetição de um sistema complexo de fatores compreendido por temperatura, níveis de oxigênio, atividade biológica e grau de acidez ou alcalinidade – potencial hidrogeniônico (pH).
“Equipamentos em escala de laboratório permitem também estabelecer métodos de avaliação e de monitoramento da geração de subprodutos, com o objetivo de aperfeiçoar, em escala industrial, a qualidade e a eficiência energética e ambiental de compostos de base orgânica e biológica”, completa o pesquisador.
O que a Embrapa espera da parceria?
Ao disponibilizar para parceria o ativo Biorreator de bancada para monitoramento da compostagem em laboratório, a Embrapa espera criar uma interface de dados interessante para o fornecimento dos resultados das análises, além de um design atrativo e inovador para o produto. É o que explica o analista Igor Dias, supervisor de prospecção e avaliação de tecnologias da Embrapa Solos.
“O parceiro deverá codesenvolver o ativo com foco nos aspectos de interface de dados e de design. Deve também se engajar na busca de clientes que possam se interessar pela adoção desta tecnologia, seja junto à comunidade acadêmica, ao setor produtivo ou em outros grupos de interesse identificados pela empresa”, completa Dias.
A Embrapa espera que o biorreator de bancada possa ser oferecido ao setor produtivo pelo parceiro por meio de venda de unidades físicas do produto ou de prestação de serviço. O modelo de negócio referente à adoção do ativo pelo mercado deverá ser fruto de negociação entre a Embrapa e o parceiro.
Os interessados na parceria devem entrar em contato com a Embrapa Solos pelo e-mail cnps.chtt@embrapa.br.
Produção brasileira de fertilizantes especiais em alta
A tecnologia dos biorreatores de bancada pode trazer ganhos importantes para a inovação nos processos de compostagem e, consequentemente, para a produção de fertilizantes orgânicos, que está em alta no Brasil.
De acordo com dados divulgados pelo Anuário de 2022 da Associação Brasileira das Indústrias de Tecnologia em Nutrição Vegetal (Abisolo), as vendas do setor de fertilizantes especiais (que incluem os minerais especiais, os organominerais e os orgânicos) atingiram R$ 16,6 bilhões em 2021, apresentando um crescimento de 65% sobre o resultado de 2020.
As três categorias tiveram crescimento robusto, sendo que as vendas de fertilizantes orgânicos apresentaram a maior variação percentual (131%), seguidos pelos organominerais (68%) e pelos minerais especiais (58%).
Em 2021, as vendas de fertilizantes minerais especiais atingiram R$ 11,943 bilhões, ante R$ 3,298 bilhões dos organominerais e R$ 1,419 bilhão dos orgânicos.
Confira também: Pesquisa da UFRGS e UEA aponta que fungos da casca-preciosa podem ser capazes de degradar plástico